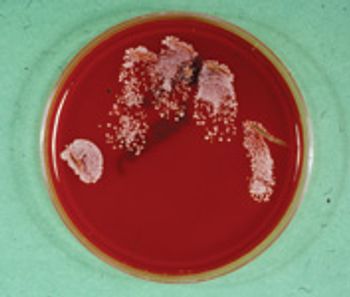

Axial pattern flaps (APF) are a type of pedicle flap that include a large direct cutaneous artery and vein.

Axial pattern flaps (APF) are a type of pedicle flap that include a large direct cutaneous artery and vein.

Disease of the ears is very common in both dogs and cats. Infectious, parasitic, neoplastic, immune related, allergic disease, foreign bodies and trauma may affect the ears.

Surgical exploration of the abdomen is performed for diagnostic, therapeutic, and prognostic purposes.

The upper airway distress syndrome is composed of thee individual conditions that cause animals to have moderate to severe inspiratory dypnea.

Surgery is performed for dogs with pituitary and adrenal-dependent disease.

Goals of this presentation are to identify physiologic and pathologic abnormalities that require attention in order to provide safe anesthesia in dogs and cats that have, or will be undergoing, penetration of the thoracic cavity.

The purpose of this paper is to provide a brief review of important aspects of perioperative management.

Castration techniques for exotic mammals include scrotal, prescrotal and abdominal surgical approaches.

Congenital portosystemic shunts usually are single vessels that develop inside or outside the liver (Photo 1). Because these vessels carry blood around the liver instead of through it, the normal hepatic processes of metabolism, storage and production are disrupted. Most animals with congenital portosystemic shunts (CPSS) present with mild to moderate clinical signs that are not life-threatening. The most critical component for their long-term treatment is restriction of dietary protein to reduce substrates for ammonia formation by colonic bacteria. Diets for dogs with CPSS should be 15 percent to 20 percent protein on a dry-matter basis, readily digestible, high in zinc and vitamin E, and low in manganese. Sources of gastrointestinal hemorrhage (gastritis, parasites), which provide additional protein substrate, should be treated. Ammonia production and absorption can be reduced by administration of lactulose, antibiotics such as neomycin or metronidazole, or unflavored yogurt with active cultures. Cystitis..

Congenital portosystemic shunts usually are single vessels that develop inside or outside the liver (Photo 1). Because these vessels carry blood around the liver instead of through it, the normal hepatic processes of metabolism, storage and production are disrupted.

Congenital portosystemic shunts (PSS) occur in 0.18 percent of all dogs, and are particularly common in Yorkshire Terriers, Maltese dogs, Pugs, Schnauzers and Shih Tzus.

A chief concern with any trauma that causes frontal or poll injury is possible damage to the central nervous system.

Leesburg, Va. - M. Norris Adams, DVM, Dipl. ACVS, joined Virginia Tech's Marion duPont Scott Equine Medical Center as a clinical assistant professor in equine lameness and surgery, focusing on elective orthopedic procedures.

EDITORS NOTE: A new collaborative column with the American College of Veterinary Surgeons (ACVS) and DVM Newsmagazine debuts this month. SurgerySTAT offers DVM readers insightful information for preoperative preparation, a surgical technique or postoperative care.
Have you read or heard about the crisis associated with methicillin-resistant Staphylococcus aureus (MRSA) that is sweeping across the United States? Hospitals, nursing homes, schools, sports facilities, correctional facilities and child day-care centers are reporting outbreaks of human nosocomial infections with methicillin-resistant staphylococci.

Oral surgery in canine and feline patients often requires extended periods of anesthesia necessitating optimal anesthetic management.

Philadelphia - Dr. Lillian R. Aronson made the record books, at least at the University of Pennsylvania.

Minneapolis - Dr. Carl Seemann plans to appeal an administrative law judge's ruling that backs state regulators' efforts to suspend his license for not administering drugs to manage a surgical patient's pain.

Columbia, Mo. - University of Missouri researchers have developed an in vitro joint model that replaces laboratory animals, cuts costs and improves safety when studying human and canine arthritis.

Although anal-sac tumors make up only 2 percent of all cutaneous neoplasms in dogs, they comprise a significant portion of the referrals to veterinary surgeons and oncologists.

This surgeon advises new graduates to see as many cases as possible early in their careers. "Experiences in dealing with animals, disease, clients, and peers will provide the intellectual, physical, and psychological supports needed for long-term survival in the clinical arena."

Rockville, MD - 11/19/07 - It's official. Charles Raker, VMD, Dipl. ACVS is a legend in veterinary surgery.

Baton Rouge - 11/14/07 - The first-time procedure for professors in the Louisiana State University School of Veterinary Medicine (LSU) has saved the life of a colleague's German Shepherd that had been suffering from congestive heart failure.

Waltham, Mass. - 10/23/07 - A local veterinary hospital is implementing a $4.5-million project that will dobule its staff, add more than half a dozen new specialties and improve its focus on patient care.

When wrapping cat paws after onychectomy, use a finger cut from a glove over some cotton and then tape it.